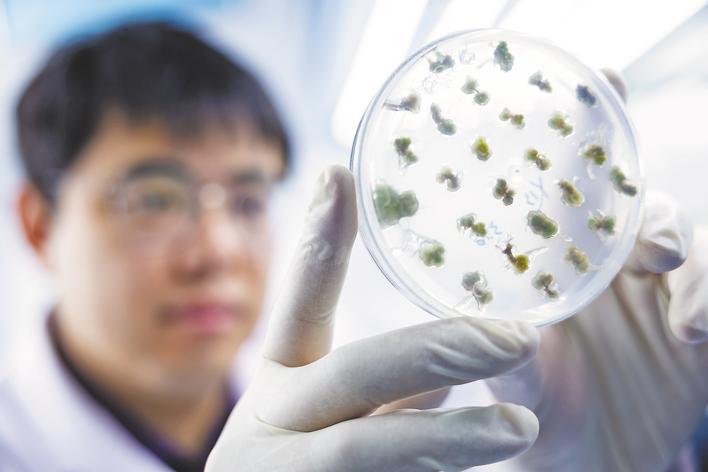

中国农科院油料所科研助理张亮观察油菜愈伤组织生长情况。 (湖北日报全媒记者 任勇 通讯员 张杨 张惠雯 摄)

在武汉国家农创中心核心功能区的中国种子生命科学技术中心,温室科学家姬晨晨在室内培养室内观察水稻秧苗生长情况。(湖北日报全媒记者 任勇 通讯员 张琼 兰娅芳 摄)

在黄冈市罗田县大河岸镇磙石坳村高标农田,收割机正在收割中稻。 (视界网 王江 摄)
一粒种子可以改变一个世界,一项技术能够创造一个奇迹。
“种业是最重要的,搞农业要把种业搞上去。”3月5日下午,习近平总书记参加江苏代表团审议时强调种业“这件大事”,在湖北种业科研工作者中引发热烈反响。
种子是农业的芯片。湖北是种质资源大省,红莲型杂交稻、油菜、彩色马铃薯、玉米等新品种走在全国前列,甚至走出国门、造福世界。湖北种业科研工作者向习近平总书记报喜:“牢记总书记殷殷嘱托,全力攻克品种短板、突破技术难关,推动科技创新与产业创新深度融合,为保障国家粮食安全、端牢中国饭碗、筑牢大国粮仓根基贡献坚实力量。”